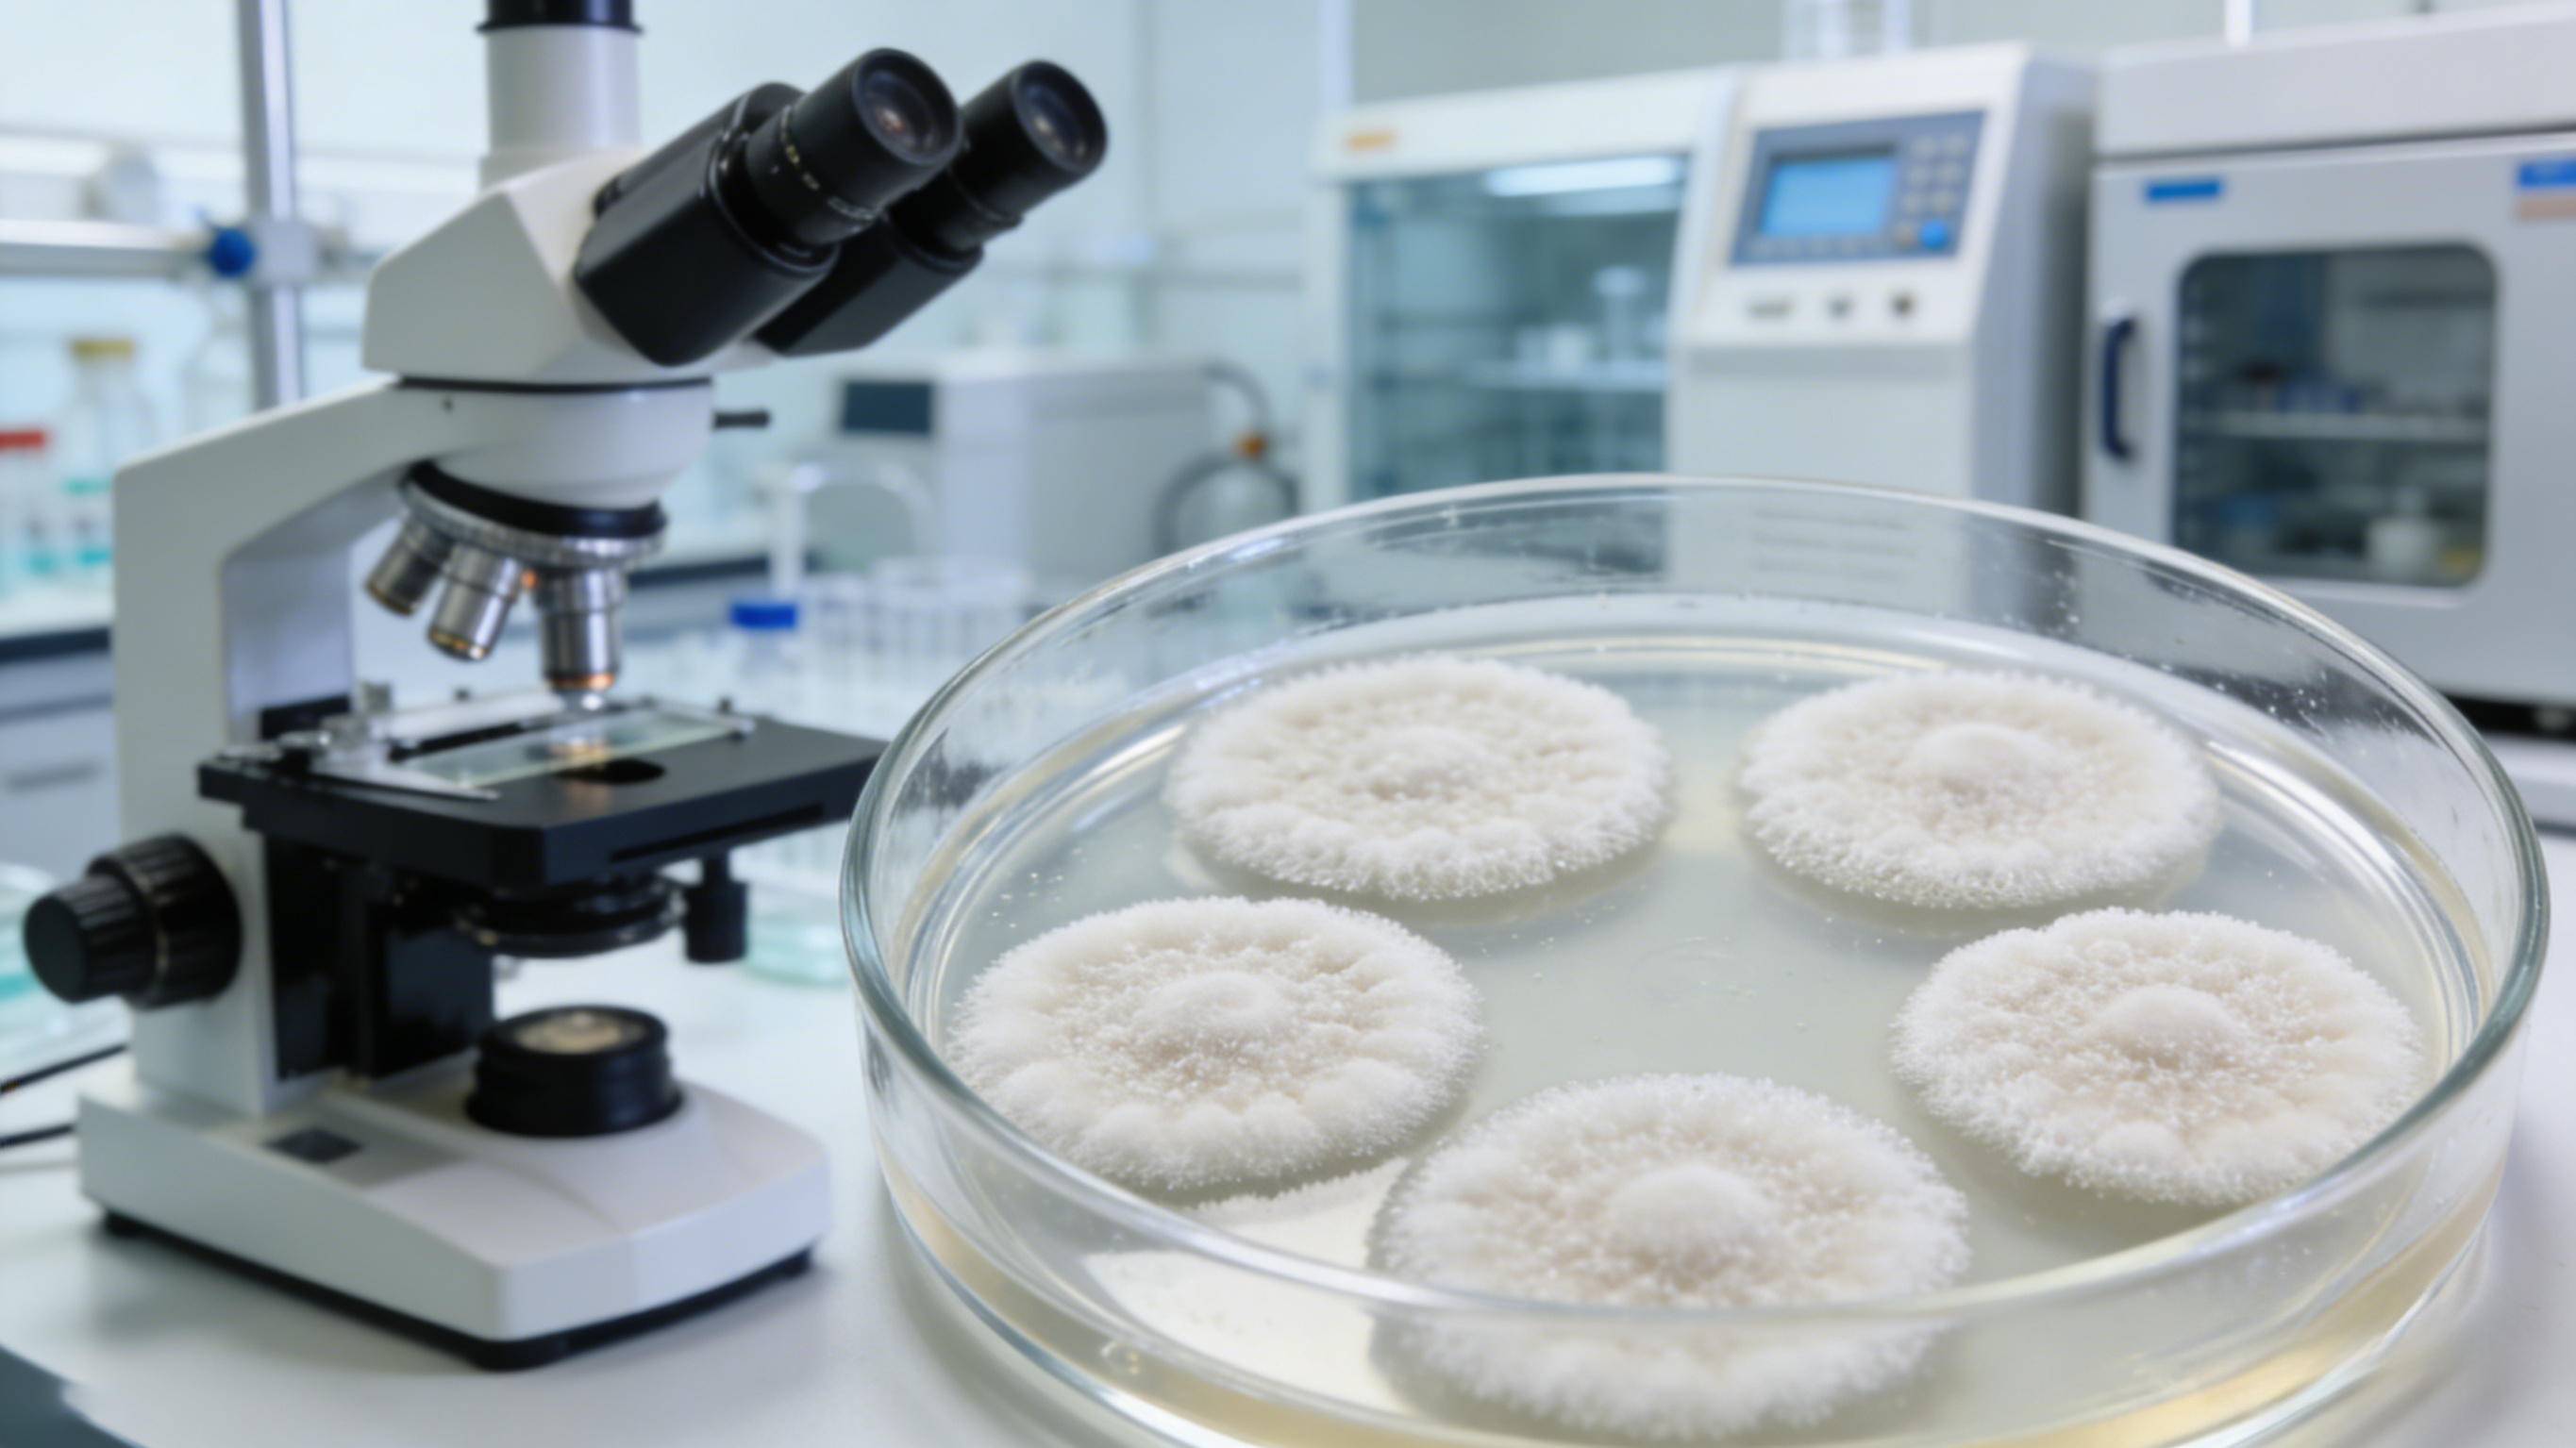

在生物制药细胞株开发的全流程中,“稳定性”始终是绕不开的核心议题——它不是可选项,而是决定细胞株能否从实验室走向工业化生产、能否实现商业价值的必备前提。很多时候,实验室中筛选出的高表达克隆,看似具备高效生产潜力,却因稳定性不足,最终无法投入规模化生产,沦为“实验室里的优秀产物”。究其根本,细胞株开发的终极目标是支撑工业化量产,而稳定性直接关联生产可靠性、产品一致性、成本可控性与法规可通过性,这四大核心需求共同决定了:稳定性是细胞株开发的必答题,而非加分题,二者之间的因果关联,贯穿生物制药工业化的全过程。
生物制药的工业化生产,本质是对细胞株“持续、稳定输出合格产物”能力的长期考验。从种子库构建、细胞传代扩增,到大规模反应器培养、多批次连续生产,细胞需要经历数十代甚至上百代的传代,还要承受培养环境波动、营养消耗、代谢产物积累等多重压力。若细胞株缺乏稳定性,任何一个环节出现基因整合丢失、目的基因沉默、表达水平下降或产物质量漂移,都将导致生产流程失控、产品不合格,甚至造成巨额经济损失。因此,细胞株开发绕不开稳定性,本质上是工业化生产的“确定性需求”决定的——只有细胞株稳定,才能实现生产过程可重复、可放大,才能将实验室的研发成果转化为规模化的商业产品。
生产可靠性:无稳定,无规模化生产的可能
工业化生产的核心诉求是“稳定、高效、可复制”,而细胞株的稳定性,是实现这一诉求的首要前提,这也是细胞株开发必须关注稳定性的核心原因之一。实验室中的高表达细胞株,若仅能在短期培养中维持高产出,而在传代扩增或长期培养中出现表达量骤降、细胞活力衰退,甚至异常增殖、凋亡比例升高,将直接导致生产工艺无法落地。
工业化生产中,细胞株需经过种子扩增、工作种子库制备、反应器分批培养等多个环节,传代次数通常达到数十代。若细胞株遗传不稳定,可能出现目的基因整合位点丢失、染色体异常,进而导致目的蛋白表达量大幅波动——例如,原本能达到1g/L的表达水平,经过十数代传代后降至0.3g/L以下,将直接导致生产批次产量不达标,生产线无法按标准流程运行。更严重的是,不稳定的细胞株可能在培养过程中突然“罢工”,导致整个培养批次报废,不仅浪费反应器运行时间、培养基等原料,更会延误生产进度,影响产品供应。
可见,稳定性是工业化生产的“压舱石”。细胞株开发绕不开稳定性,正是因为只有稳定的细胞株,才能确保生产过程的连续性和可重复性,才能让规模化生产从“可能”变为“现实”。若忽视稳定性,即便筛选出
高表达克隆,也无法支撑工业化生产的长期需求,最终只能停留在实验室阶段。
产品一致性:无稳定,无合格药品的保障

生物制药产品(如单克隆抗体、重组蛋白等)的质量直接关系到临床疗效和用药安全,而细胞株的稳定性,是决定产品质量一致性的关键因素——这也是细胞株开发绕不开稳定性的核心逻辑之一。与化学制药不同,生物制药的产物是细胞代谢的产物,其质量属性(如糖基化修饰、聚体含量、电荷异质性等)高度依赖于细胞的生理状态和表达环境,而细胞株的稳定性,直接决定了细胞在长期生产过程中能否维持稳定的生理状态和表达特性。
若细胞株不稳定,在传代或培养过程中出现基因表达调控异常,可能导致目的蛋白的结构发生改变——例如,糖基化修饰异常可能影响蛋白的半衰期和免疫原性,聚体含量过高可能引发不良反应,电荷异质性超标可能导致药效下降。这些质量异常,不仅会导致产品不合格,更可能给临床用药带来安全风险。而工业化生产要求每一批次产品的质量保持高度一致,这种一致性的实现,必须以细胞株的稳定性为基础:只有细胞株稳定表达,才能确保每一批次产物的质量属性符合标准,才能保障药品的临床疗效和安全性。
从因果关系来看,细胞株的稳定性是“因”,产品质量的一致性是“果”。细胞株开发绕不开稳定性,本质上是为了守住药品质量的底线,确保每一批次产品都能达到临床使用的标准,这也是生物制药行业的核心责任所在。
成本可控性:无稳定,无商业可行的价值

生物制药工业化生产的成本极高,涉及细胞株开发、培养基采购、反应器运行、人力投入、质量检测等多个环节,而细胞株的不稳定性,会直接导致生产成本大幅上升,甚至让项目失去商业可行性——这也是细胞株开发必须关注稳定性的现实考量。
一方面,细胞株开发周期长、投入大,一个商业化细胞株的开发往往需要数月甚至数年时间,涉及大量的克隆筛选、验证工作。若筛选出的细胞株稳定性不足,无法满足工业化生产需求,就需要重新筛选克隆、重新开展工艺验证,不仅会延长开发周期,更会导致前期的人力、物力、财力投入全部白费。另一方面,在工业化生产过程中,不稳定的细胞株会导致批次报废率升高——每一批次的反应器运行、培养基消耗、人力投入都堪称“巨额成本”,一旦批次报废,这些投入都将无法收回。此外,不稳定的细胞株可能需要频繁调整培养条件、增加质量检测频次,进一步增加生产过程中的人力和物料成本。
相反,
稳定的细胞株能够有效降低生产风险,减少批次报废率,确保生产过程的连续性和高效性。同时,稳定的细胞株无需频繁调整工艺参数,能够简化生产流程、降低质量检测成本,进而实现整个工业化生产流程的成本优化。因此,细胞株开发绕不开稳定性,是实现成本可控、保障项目商业可行性的必然选择。
法规可通过性:无稳定,无产品上市的可能
生物制药产品的上市,必须通过各国药品监管机构(如中国NMPA、美国FDA、欧洲EMA等)的严格审批,而细胞株的稳定性研究,是法规审批的核心要求之一——这也是细胞株开发绕不开稳定性的硬性约束。没有稳定的细胞株,就无法满足法规要求,即便产品质量在实验室阶段达标,也无法通过审批实现上市,最终无法转化为商业价值。
各国药监机构明确要求,生物制药企业在申报新药时,必须提供充分的细胞株稳定性数据,包括传代稳定性、基因整合稳定性、目的蛋白表达水平稳定性、产物质量稳定性等。例如,通常要求细胞株在模拟工业化生产的传代条件下(如传代≥60代),仍能维持稳定的基因整合状态、表达水平和产物质量,确保生产过程中每一批次产品的质量可控。若无法提供合格的稳定性数据,药监机构将认为该细胞株无法满足工业化生产的要求,不予批准上市。
这意味着,稳定性是细胞株走向市场的“通行证”。细胞株开发绕不开稳定性,本质上是法规要求决定的,是产品能够顺利上市、实现商业价值的必备条件。忽视稳定性研究,即便筛选出高表达的克隆,也可能因无法通过法规审批而功亏一篑。
结语:稳定性,是细胞株开发的核心底线
综上,细胞株开发之所以绕不开稳定性,核心在于稳定性与工业化生产的四大核心需求(生产可靠性、产品一致性、成本可控性、法规可通过性)存在直接的因果关系——稳定性是因,四大需求的实现是果。细胞株开发的终极目标,从来不是单纯追求高表达,而是培育出“稳定且高效”的细胞株,因为只有稳定的细胞株,才能支撑起规模化、标准化的工业化生产,才能保障产品质量的稳定可靠,才能控制生产成本、满足法规要求,最终实现生物制药的商业价值和临床价值。
在生物制药行业竞争日益激烈的今天,稳定性已成为细胞株开发的核心底线。忽视稳定性,就等于放弃了工业化生产的可行性,放弃了产品上市的机会。因此,在细胞株开发的每一个环节——从克隆筛选、基因整合,到传代验证、工艺优化,都应将稳定性作为核心指标,持续关注、严格把控,唯有如此,才能培育出符合工业化生产需求的细胞株,推动生物制药行业高质量发展。